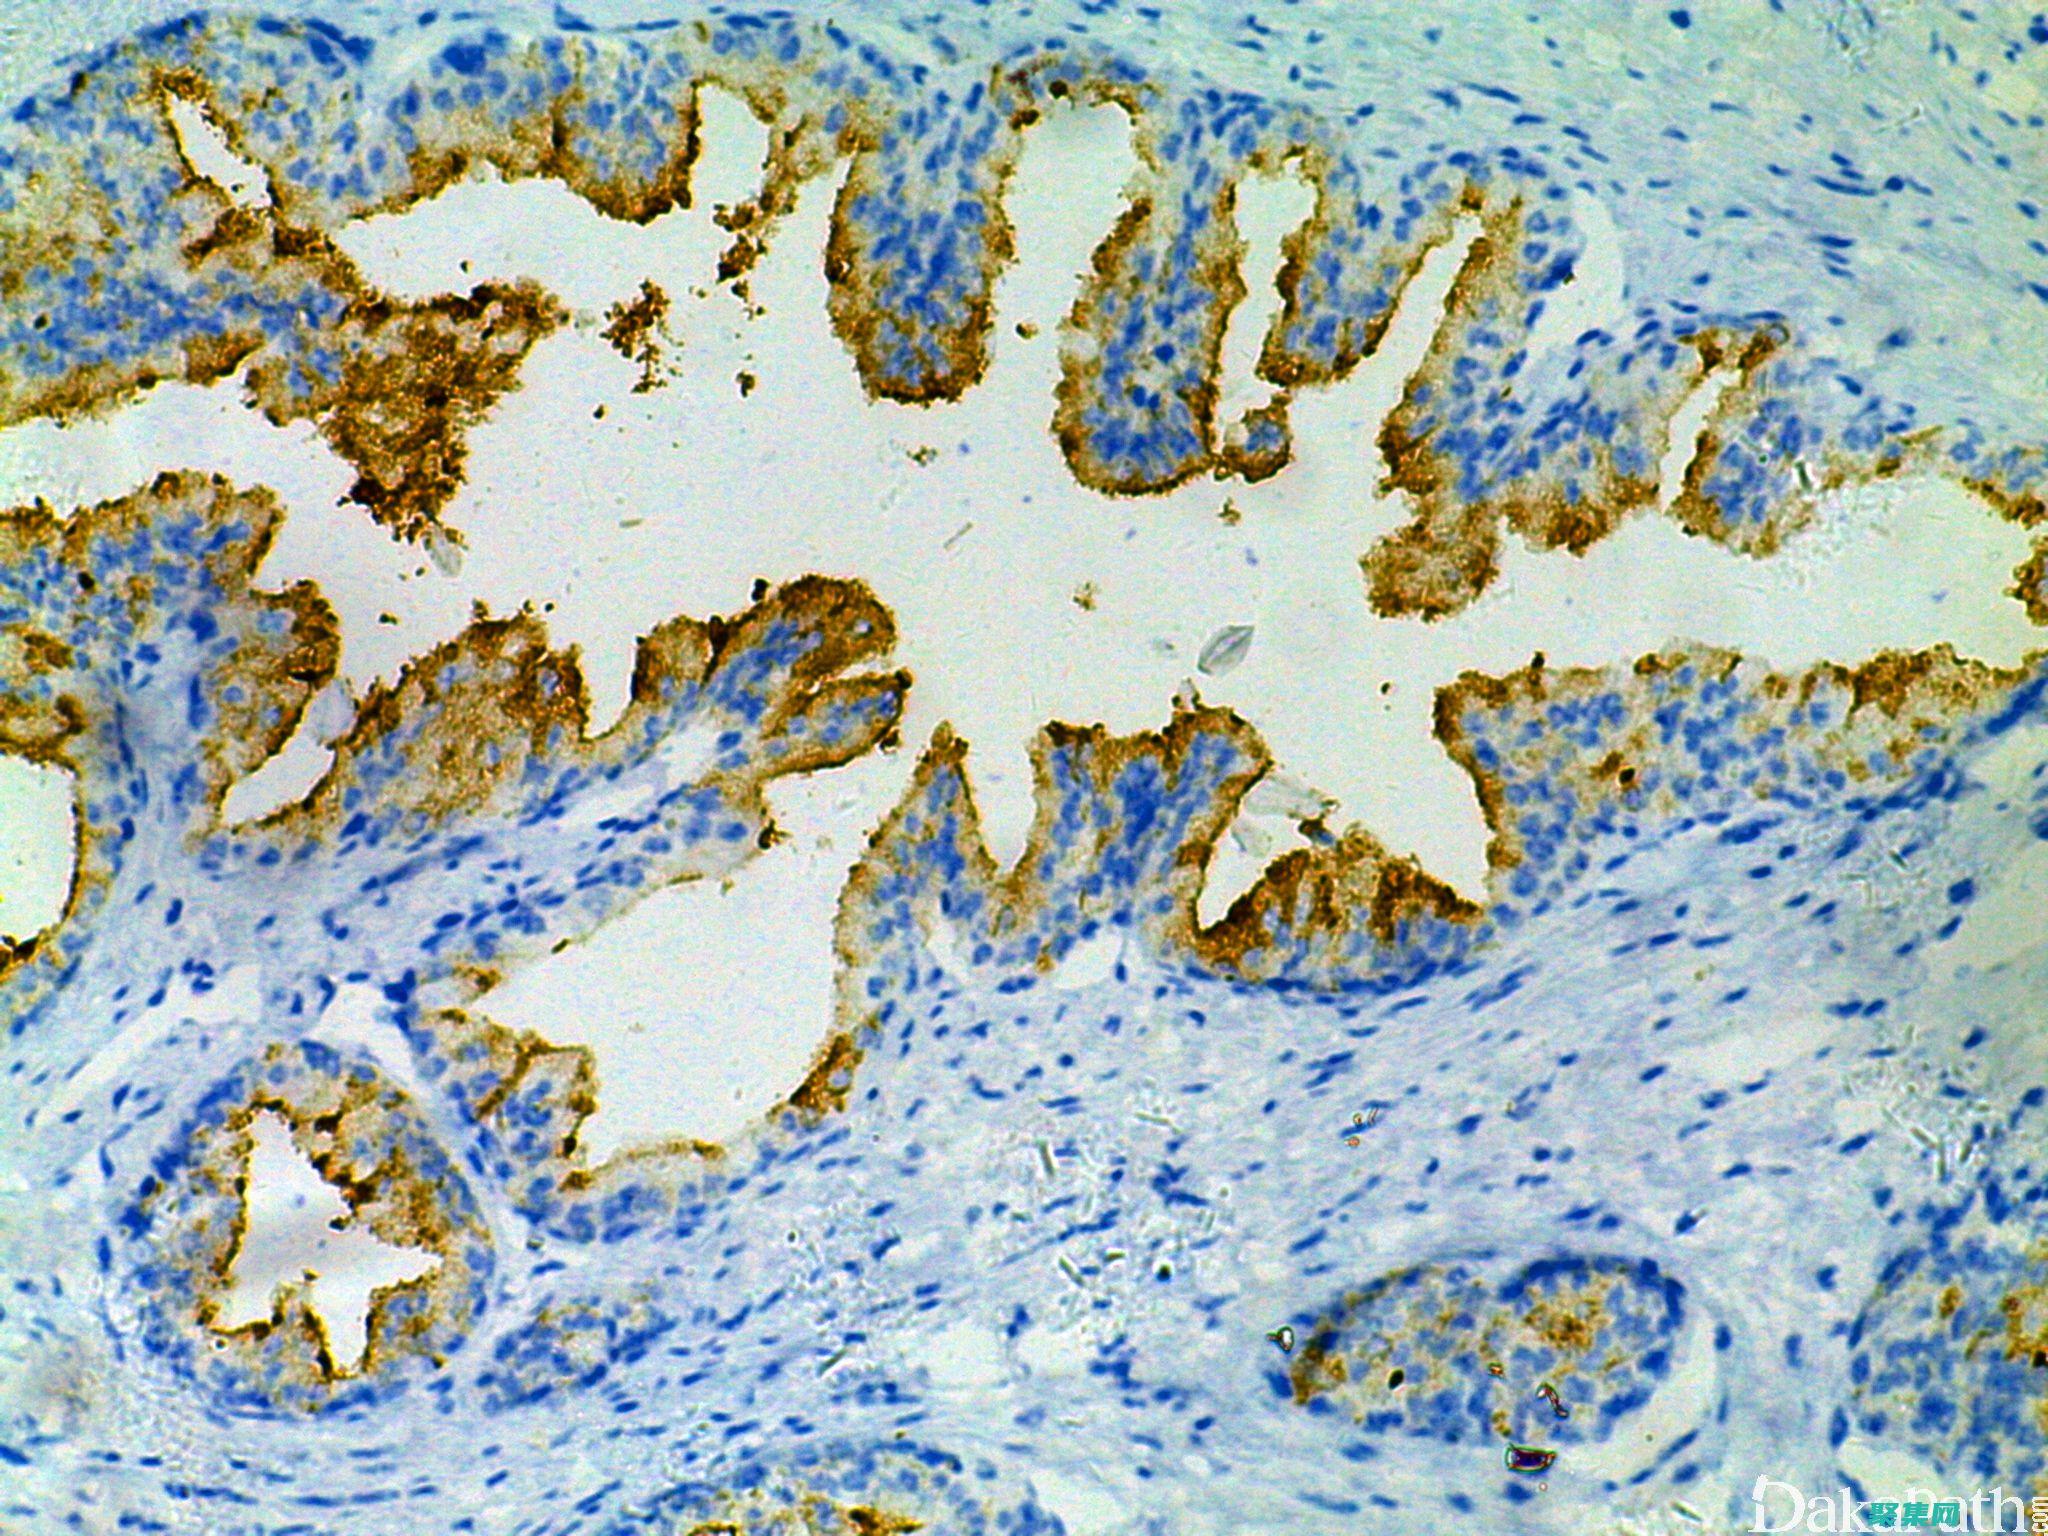
社區資源

文章編號:7355時間:2024-09-16人氣:

內容聲明:
1、本站收錄的內容來源于大數據收集,版權歸原網站所有!
2、本站收錄的內容若侵害到您的利益,請聯系我們進行刪除處理!
3、本站不接受違法信息,如您發現違法內容,請聯系我們進行舉報處理!
4、本文地址:http://www.lmxpnzry.com/article/5a882fa30ef6678f7add.html,復制請保留版權鏈接!

微妙的動畫效果可以極大地提升用戶體驗,增加互動性和吸引力,下面介紹幾種巧妙運用動畫效果提升用戶體驗的方法,1.提供視覺反饋通過在用戶操作后添加動畫效果,可以提供即時視覺反饋,例如,當用戶點擊按鈕時,按鈕可以上下彈跳,表示操作已成功,這種反饋提升了互動性,讓用戶明確自己的操作已得到響應,2.引導用戶注意力動畫效果可以引導用戶的注意力,將...。
本站公告 2024-09-16 01:01:49

JavaServerPages,JSP,是一種基于Java的技術,用于開發動態Web頁面,JSTL控制流程標簽可提供靈活的方式控制JSP頁面中的代碼執行流,通過使用這些標簽,開發人員可以創建條件語句、循環和迭代器,以根據不同的條件處理數據,JSTL控制流程標簽JSTL定義了一系列用于控制流程的標簽,包括,``,執行條件語句``,執行多...。
本站公告 2024-09-15 14:21:49

定義取整函數是指將一個實數近似為其最接近的整數的函數,在數學中,取整函數通常表示為`floor,`、`ceil,`和`round,`函數,`floor,`函數返回小于或等于給定實數的最大整數,`ceil,`函數返回大于或等于給定實數的最小整數,`round,`函數返回最接近給定實數的整數,類型根據取整函數的輸出結果,可以將...。
技術教程 2024-09-12 23:33:54

概覽Java虛擬機,JVM,是Java語言的核心組件,它負責執行Java字節碼并提供運行時環境,本文將提供Java虛擬機從下載到部署的完整解析,幫助廣大開發者深入理解其工作原理和使用技巧,下載Java虛擬機第一步是下載與您的操作系統兼容的Java虛擬機,您可以從Oracle的官方網站或其他第三方提供商那里下載JVM,Oracle官方網...。
最新資訊 2024-09-12 19:39:45

前言余切函數在計算機圖形學中扮演著至關重要的角色,尤其是在三維旋轉和透視投影方面,這些技術被廣泛應用于游戲、電影和仿真中,以創造逼真的三維場景,余切函數余切函數是一個三角函數,定義為對角線與鄰邊的比率,在單位圓上,它表示從原點到給定角度的對邊線的垂直距離,余切函數的定義如下,$$\tan,\theta,=\frac,\sin,\the...。
本站公告 2024-09-11 19:00:47

在當今數字化世界中,數據已經成為我們生活的至關重要部分,從個人照片和視頻到重要商業文件和財務記錄,我們依賴數據來保持聯系、完成工作和管理我們的財務,數據丟失的風險是真實存在的,硬盤故障、病毒攻擊、自然災害或盜竊都可能導致數據丟失,因此,至關重要的是采取措施來保護我們的寶貴數據,而備份就是最佳方式,3,2,1備份規則3,2,1備份規則是...。
本站公告 2024-09-11 13:32:35

前言中國作為全球數字化大國,對于開發者而言是一個充滿機遇的沃土,為了助力中國開發者茁壯成長,本文匯集了豐富的資源和支持,旨在為他們的職業發展提供全方位的賦能,教育與培訓在線課程平臺網易云課堂,提供海量免費和付費課程,涵蓋從基礎編程到高級技術,Coursera,與世界名校合作,提供計算機科學、數據科學和AI等領域的認證課程,Udemy,...。
互聯網資訊 2024-09-09 10:03:16

商業源碼免費下載歡迎來到商業源碼網,這是一個致力于滿足不同行業商業需求的平臺,我們提供各種定制源碼和服務,助力你的企業取得成功,我們提供的服務定制源碼,提供適用于不同行業和業務規模的定制源碼解決方案,包括電子商務、CRM、ERP、CMS等,開發服務,從需求分析到代碼實現和維護,提供全方位的開發服務,滿足你的特定需求,咨詢服務,提供業務...。
本站公告 2024-09-09 09:09:36

圖表控件是交互式計算機可視化工具,用于以圖形方式表示數據,它們允許用戶輕松地展示和分析復雜的數據集,并獲得有意義的見解,圖表控件類型有各種各樣的圖表控件可用,每種控件都適合不同的數據類型和可視化目的,一些常見的圖表類型包括,條形圖,比較不同類別或子類別的值折線圖,顯示數據隨時間的變化餅圖,顯示數據的百分比組成散點圖,探索兩個變量之間的...。
本站公告 2024-09-08 20:39:31

定義成果評估和影響評估是評價項目、計劃或政策有效性和影響的過程,成果評估關注于項目的即時產出,而確定評估的目的是什么,2.選擇評估方法,確定將用于評估項目的評估方法,3.收集數據,收集有關項目產出和影響的信息,4.分析數據,分析收集的數據以確定項目是否有效,5.報告結果,編寫評估報告總結結果并提出建議,挑戰評估成果和影響可能面臨許多挑...。
技術教程 2024-09-08 05:45:08

哈希表是一種數據結構,用于在平均情況下以恒定的時間復雜度存儲和檢索數據,它使用稱為哈希函數的函數將鍵映射到哈希表中的索引,從而實現快速查找,哈希表主要用于存儲變量和對象的引用,它不像文件存儲系統那樣直接存儲文件,相反,它存儲指向存儲在文件系統中的文件的指針或引用,哈希表的工作原理哈希表由一系列存儲單元,稱為桶,組成,每個桶存儲一組鍵值...。
互聯網資訊 2024-09-06 00:49:08

1、擁有自己的域名和服務器域名就相當于你的名字,所以域名要簡單好記,最好能體現你電商平臺的屬性,這個不在強求,,服務器,最好是自己單獨購買一個服務器,因為一旦牽涉到交易等私密信息,獨立部署是必須要的,2、確定電子商務平臺的開發語言以及數據庫電子商務平臺的開發語言種類較多,ASP、PHP和JSP這些都是可以實現編輯平臺的語言,如果你有自...。
技術教程 2024-09-02 01:46:55